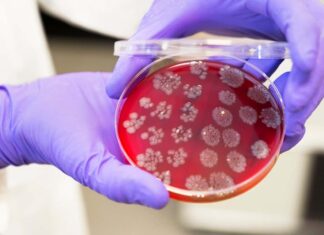
Faecal transplants could boost the effectiveness of cancer treatments Faecal transplants could boost the effectiveness of cancer treatments

Macron warns of ‘world without rules’ after Trump shares texts from European leaders
French President Emmanuel Macron says Europe will not give in to bullies or be intimidated, in a scathing criticism of US President Donald Trump's threat to impose steep tariffs if Europe does not let him take over Greenland. While other European leaders have tried to keep a measured tone to prevent the trans-Atlantic dispute from
Le lait infantile est-il devenu trop complexe pour être totalement sûr ?
Chacun sait que, de très loin, le meilleur aliment pour le bébé est le lait de sa propre mère. Parmi les mammifères , il n'y a que les humains pour tenter une autre solution ! Solution parfaitement respectable et dorénavant au libre choix de la mère, mais qui n'est pas sans conséquence. Tout d'abord, dans les
Six people confirmed missing after landslide at New Zealand campground
Six people have been confirmed missing in a landslide that ripped through a busy campground on New Zealand's North Island, as emergency crews continue to comb through the rubble. Heavy rains triggered the landslide at 9.30am on Thursday (local time) at Mount Maunganui on the island's east coast, bringing soil and rubble down on the
A drying climate is making East Africa pull apart faster
(Image credit: Paul & Paveena Mckenzie/Getty Images) Over the past 5,000 years, East Africa has dried out. Now, new research finds that this change may be making the continent pull apart faster. Faults in the East African Rift Zone have sped up since the levels of large lakes have dropped, according to research published in
Harpoane din oase de balenă, vechi de 5.000 de ani, descoperite întâmplător
Harpoane confecționate din oase de balenă arată că grupuri indigene de pe teritoriul actual al Braziliei vânau balene în urmă cu 5.000 de ani. Descoperirea, care a inclus 118 oase de balenă și artefacte prelucrate, arată că vânătoarea preistorică de balene nu era limitată la populații din climatele temperate și polare ale emisferei nordice, potrivit
The “Stealth” Strategy Pays Off: UARX Space Emerges as Europe’s High-Reliability Powerhouse
NIGRÁN, Spain — While much of the European NewSpace ecosystem has spent the last five years in a cycle of public fundraising and prototype announcements, UARX Space took a different path. Founded in 2020, the company remained in a self-imposed stealth mode, focusing on the rigorous engineering required to reach Technology Readiness Level 9 (TRL9)
Best of the World 2026: Best wellness destinations
Our 2026 Best of the World list inspired you to hike South Korea from coast to coast, take an iconic road trip along Route 66, or plan a once-in-a-lifetime big five safari. For our Best of the World Wellness Experiences list, we hope to inspire you to slow down. From seaweed bathing in Ireland to
Faecal transplants could boost the effectiveness of cancer treatments
Bacteria in stools could be an unexpected weapon in the fight against cancer LEWIS HOUGHTON/SCIENCE PHOTO LIBRARY For people not responding to a type of cancer treatment, a faecal transplant from someone who had success with the drug could boost their odds. Altering the gut microbiome has knock-on effects on the immune system, which seemed
James Webb telescope solves mystery of ‘forever young’ vampire stars from the dawn of...
Researchers analyzed blue straggler stars in 48 galactic globular clusters of diverse sizes, ages, densities, distances and metallicities. This image shows the difference between a loose cluster and a dense cluster. (Image credit: ESA/Hubble & NASA) Astronomers have solved the mystery of how some stars stay youthfully bright and blue, despite being almost as old
Sunspot launches 27 solar flares in 24 hours, including strongest outburst in years
Four X-class solar flares erupted from the sun on Feb. 1-2. NASA's Solar Dynamics Observatory captures these images of the outbursts. (Image credit: NASA/SDO) A monster sunspot is taking aim at Earth after firing off dozens of powerful flares Sunday and Monday (Feb. 1-2) — including the most intense solar eruption in years. Elevated geomagnetic